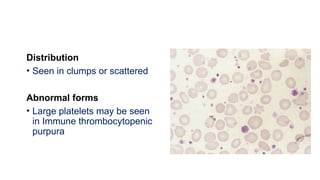
Distribution
• Seen in clumps or scattered
Abnormal forms
• Large platelets may be seen
in Immune thrombocytopenic
purpura

The document outlines the indications and methodology for peripheral smear examination, which assesses the morphology and cellularity of blood components. It details the evaluation of red blood cells, white blood cells, and platelets, along with various abnormalities such as rouleaux formation, agglutination, and multiple types of cells observed in different conditions. The document also provides specific descriptions for various blood cell shapes and their clinical significance.